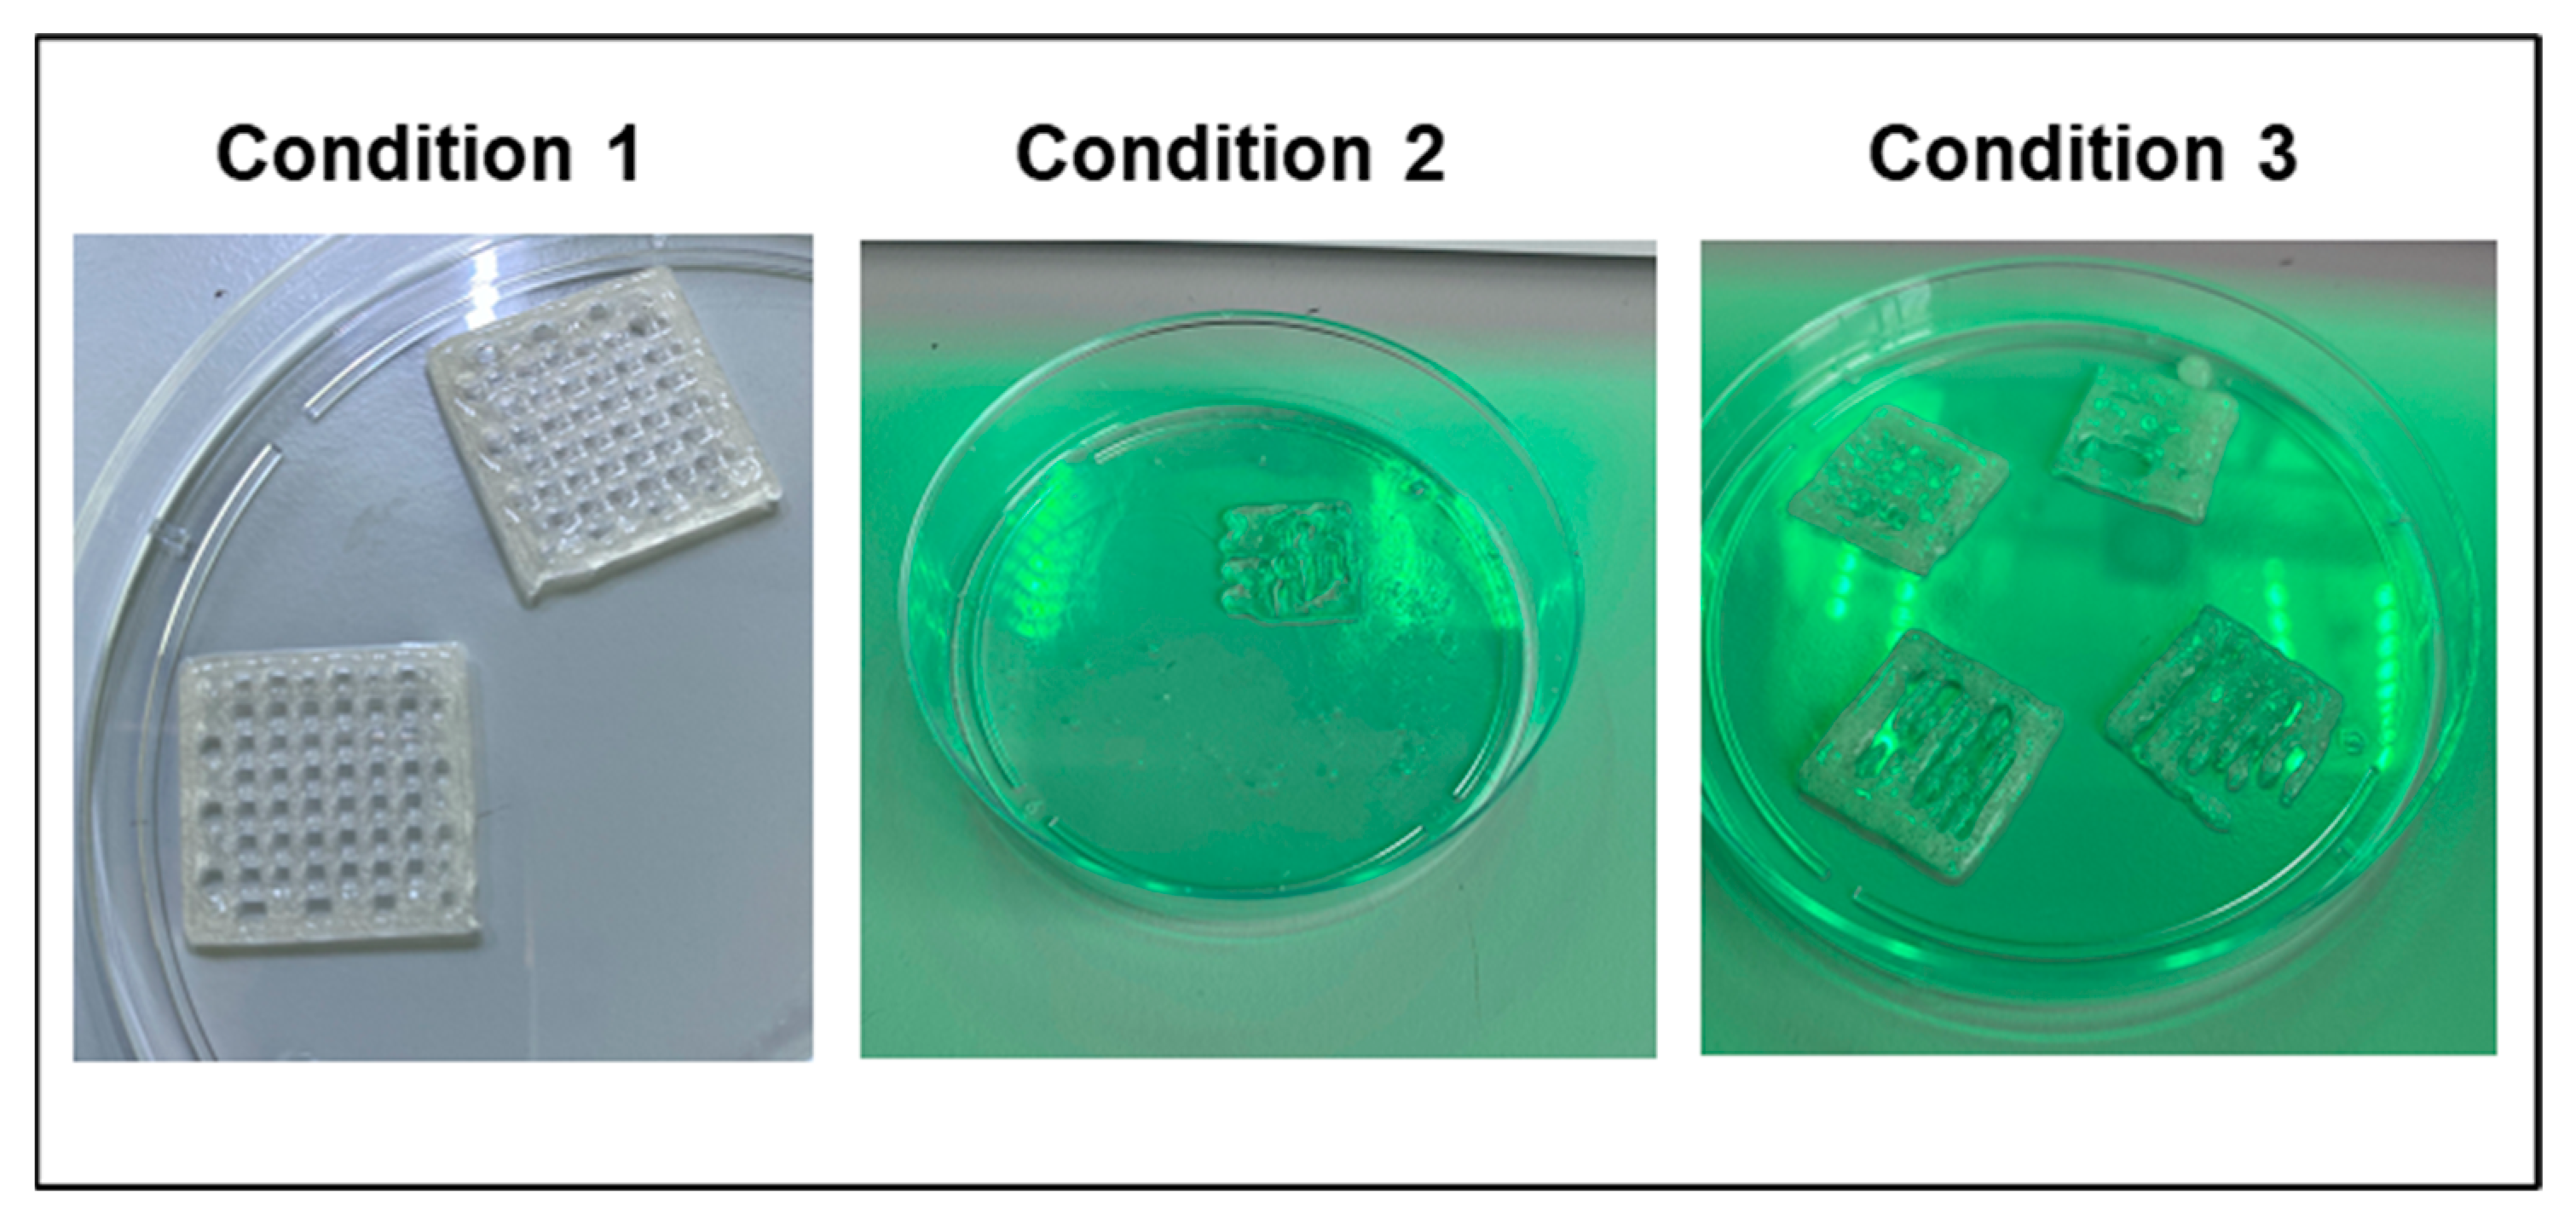
Polymers 14 04506 g001

Design of a New 3D Gelatin—Alginate Scaffold Loaded with Cannabis sativa Oil
Abstract
1. Introduction
2. Materials and Methods
2.1. Synthesis of Gelatin and Alginate Bioink
2.2. Bioprinting Parameters
2.3. Rheological Properties
2.4. Cross-Linking of the GEL–ALG Scaffolds
2.5. GEL–ALG Scaffolds Characterization
2.5.1. GEL–ALG Scaffolds Lyophilization
2.5.2. GEL–ALG Scaffolds Swelling
2.5.3. GEL–ALG Scaffolds Scanning Electron Microscopy (SEM)
2.5.4. Cytotoxicity Experiments
2.6. Addition of Cannabis sativa Oil to GEL–ALG Scaffold (GEL–ALG–CS Scaffold)
2.6.1. Fourier Transform Infrared (FTIR) Analysis
2.6.2. Scaffold Enzymatic Degradation
2.6.3. Antioxidant Capacity
2.6.4. Antimicrobial Activity
2.6.5. Biocompatibility
2.7. Sterilization
2.8. Statistical Analysis
3. Results and Discussion
3.1. Synthesis and Characterization of Gelatin and Alginate Bioink
3.2. Addition of Cannabis sativa Oil to GEL–ALG Scaffold (GEL–ALG–CS Scaffold)
3.2.1. Antioxidant Activity
3.2.2. Antimicrobial Activity
3.2.3. Biocompatibility of GEL–ALG–CS Scaffolds
4. Conclusions
Author Contributions
Funding
Institutional Review Board Statement
Informed Consent Statement
Data Availability Statement
Conflicts of Interest
References
- Schwab, A.; Hélary, C.; Richards, R.; Alini, M.; Eglin, D.; D’Este, M. Tissue mimetic hyaluronan bioink containing collagen fibers with controlled orientation modulating cell migration and alignment. Mater. Today Bio 2020, 7, 100058. [Google Scholar] [CrossRef] [PubMed]
- Frayssinet, A.; Petta, D.; Illoul, C.; Haye, B.; Markitantova, A.; Eglin, D.; Mosser, G.; D’Este, M.; Hélary, C. Extracellular matrix-mimetic composite hydrogels of cross-linked hyaluronan and fibrillar collagen with tunable properties and ultrastructure. Carbohydr. Polym. 2020, 236, 116042. [Google Scholar] [CrossRef] [PubMed]
- Nussbaum, S.R.; Carter, M.J.; Fife, C.E.; DaVanzo, J.; Haught, R.; Nusgart, M.; Cartwright, D. An Economic Evaluation of the Impact, Cost, and Medicare Policy Implications of Chronic Nonhealing Wounds. Value Health 2018, 21, 27–32. [Google Scholar] [CrossRef] [PubMed]
- Darwin, E.; Tomic-Canic, M. Healing Chronic Wounds: Current Challenges and Potential Solutions. Curr. Dermatol. Rep. 2018, 7, 296–302. [Google Scholar] [CrossRef]
- Antezana, P.E.; Municoy, S.; Álvarez-Echazú, M.I.; Santo-Orihuela, P.L.; Catalano, P.N.; Al-Tel, T.H.; Kadumudi, F.B.; Dolatshahi-Pirouz, A.; Orive, G.; Desimone, M.F. The 3D Bioprinted Scaffolds for Wound Healing. Pharmaceutics 2022, 14, 464. [Google Scholar] [CrossRef]
- Buj-Corral, I.; Sanz-Fraile, H.; Ulldemolins, A.; Tejo-Otero, A.; Domínguez-Fernández, A.; Almendros, I.; Otero, J. Characterization of 3D Printed Metal-PLA Composite Scaffolds for Biomedical Applications. Polymers 2022, 14, 2754. [Google Scholar] [CrossRef]
- Jusoh, W.N.L.W.; Sajab, M.S.; Abdul, P.M.; Kaco, H. Recent Advances in 3D Bioprinting: A Review of Cellulose-Based Biomaterials Ink. Polymers 2022, 14, 2260. [Google Scholar] [CrossRef]
- Tsegay, F.; Elsherif, M.; Butt, H. Smart 3D Printed Hydrogel Skin Wound Bandages: A Review. Polymers 2022, 14, 1012. [Google Scholar] [CrossRef]
- Liu, S.; Wang, T.; Li, S.; Wang, X. Application Status of Sacrificial Biomaterials in 3D Bioprinting. Polymers 2022, 14, 2182. [Google Scholar] [CrossRef]
- Mobaraki, M.; Ghaffari, M.; Yazdanpanah, A.; Luo, Y.; Mills, D. Bioinks and bioprinting: A focused review. Bioprinting 2020, 18, e00080. [Google Scholar] [CrossRef]
- Echazú, M.I.A.; Perna, O.; Olivetti, C.E.; Antezana, P.E.; Municoy, S.; Tuttolomondo, M.V.; Galdopórpora, J.M.; Alvarez, G.S.; Olmedo, D.G.; Desimone, M.F. Recent Advances in Synthetic and Natural Biomaterials-Based Therapy for Bone Defects. Macromol. Biosci. 2022, 22, 2100383. [Google Scholar] [CrossRef] [PubMed]
- Liu, F.; Wang, X. Synthetic Polymers for Organ 3D Printing. Polymers 2020, 12, 1765. [Google Scholar] [CrossRef] [PubMed]
- Kim, S.D.; Jin, S.; Kim, S.; Son, D.; Shin, M. Tyramine-Functionalized Alginate-Collagen Hybrid Hydrogel Inks for 3D-Bioprinting. Polymers 2022, 14, 3173. [Google Scholar] [CrossRef] [PubMed]
- Smandri, A.; Nordin, A.; Hwei, N.M.; Chin, K.-Y.; Abd Aziz, I.; Fauzi, M.B. Natural 3D-Printed Bioinks for Skin Regeneration and Wound Healing: A Systematic Review. Polymers 2020, 12, 1782. [Google Scholar] [CrossRef]
- Benwood, C.; Chrenek, J.; Kirsch, R.; Masri, N.; Richards, H.; Teetzen, K.; Willerth, S. Natural Biomaterials and Their Use as Bioinks for Printing Tissues. Bioengineering 2021, 8, 27. [Google Scholar] [CrossRef]
- Choi, Y.-J.; Park, H.; Ha, D.-H.; Yun, H.-S.; Yi, H.-G.; Lee, H. 3D Bioprinting of In Vitro Models Using Hydrogel-Based Bioinks. Polymers 2021, 13, 366. [Google Scholar] [CrossRef]
- Lukin, I.; Erezuma, I.; Maeso, L.; Zarate, J.; Desimone, M.F.; Al-Tel, T.H.; Dolatshahi-Pirouz, A.; Orive, G. Progress in Gelatin as Biomaterial for Tissue Engineering. Pharmaceutics 2022, 14, 1177. [Google Scholar] [CrossRef]
- Peng, B.-Y.; Ou, K.-L.; Liu, C.-M.; Chu, S.-F.; Huang, B.-H.; Cho, Y.-C.; Saito, T.; Tsai, C.-H.; Hung, K.-S.; Lan, W.-C. A Three-Dimensional Bioprinted Copolymer Scaffold with Biocompatibility and Structural Integrity for Potential Tissue Regeneration Applications. Polymers 2022, 14, 3415. [Google Scholar] [CrossRef]
- Sánchez-Cid, P.; Jiménez-Rosado, M.; Romero, A.; Pérez-Puyana, V. Novel Trends in Hydrogel Development for Biomedical Applications: A Review. Polymers 2022, 14, 3023. [Google Scholar] [CrossRef]
- Leucht, A.; Volz, A.-C.; Rogal, J.; Borchers, K.; Kluger, P.J. Advanced gelatin-based vascularization bioinks for extrusion-based bioprinting of vascularized bone equivalents. Sci. Rep. 2020, 10, 5330. [Google Scholar] [CrossRef]
- Luo, W.; Song, Z.; Wang, Z.; Wang, Z.; Li, Z.; Wang, C.; Liu, H.; Liu, Q.; Wang, J. Printability Optimization of Gelatin-Alginate Bioinks by Cellulose Nanofiber Modification for Potential Meniscus Bioprinting. J. Nanomater. 2020, 2020, 3863428. [Google Scholar] [CrossRef]
- Li, S.; Fan, M.; Deng, S.; Tao, N. Characterization and Application in Packaging Grease of Gelatin–Sodium Alginate Edible Films Cross-Linked by Pullulan. Polymers 2022, 14, 3199. [Google Scholar] [CrossRef]
- Babi, M.M.; Hofmann, S.; Müller, R.; Tomi, S.L. Bioactive Interpenetrating Hydrogel Networks Based on 2-Hydroxyethyl Methacrylate and Gelatin Intertwined with Alginate and Dopped with Apatite as Scaffolding Biomaterials. Polymers 2022, 14, 3112. [Google Scholar]
- Zhang, X.; Wang, X.; Fan, W.; Liu, Y.; Wang, Q.; Weng, L. Fabrication, Property and Application of Calcium Alginate Fiber: A Review. Polymers 2022, 14, 3227. [Google Scholar] [CrossRef] [PubMed]
- Raus, R.A.; Nawawi, W.M.F.W.; Nasaruddin, R.R. Alginate and alginate composites for biomedical applications. Asian J. Pharm. Sci. 2021, 16, 280–306. [Google Scholar] [CrossRef]
- Rastogi, P.; Kandasubramanian, B. Review of alginate-based hydrogel bioprinting for application in tissue engineering. Biofabrication 2019, 11, 042001. [Google Scholar] [CrossRef] [PubMed]
- Datta, S.; Barua, R.; Das, J. Importance of Alginate Bioink for 3D Bioprinting in Tissue Engineering and Regenerative Medicine. In Alginates—Recent Uses of This Natural Polymer; IntechOpen: London, UK, 2020. [Google Scholar] [CrossRef]
- Sharma, A.; Khanna, S.; Kaur, G.; Singh, I. Medicinal plants and their components for wound healing applications. Futur. J. Pharm. Sci. 2021, 7, 53. [Google Scholar] [CrossRef]
- Echazú, M.I.A.; Olivetti, C.E.; Peralta, I.; Alonso, M.R.; Anesini, C.; Perez, C.J.; Alvarez, G.S.; Desimone, M.F. Development of PH-Responsive Biopolymer-Silica Composites Loaded with Larrea Divaricata Cav. Extract with Antioxidant Activity. Colloids Surfaces B Biointerfaces 2018, 169, 82–91. [Google Scholar] [CrossRef] [PubMed]
- Palierse, E.; Hélary, C.; Krafft, J.-M.; Génois, I.; Masse, S.; Laurent, G.; Echazu, M.I.A.; Selmane, M.; Casale, S.; Valentin, L.; et al. Baicalein-modified hydroxyapatite nanoparticles and coatings with antibacterial and antioxidant properties. Mater. Sci. Eng. C 2021, 118, 111537. [Google Scholar] [CrossRef]
- Odieka, A.E.; Obuzor, G.U.; Oyedeji, O.O.; Gondwe, M.; Hosu, Y.S.; Oyedeji, A.O. The Medicinal Natural Products of Cannabis Sativa Linn.: A Review. Molecules 2022, 27, 1689. [Google Scholar] [CrossRef]
- Chandra, S.; Lata, H.; ElSohly, M.A. Propagation of Cannabis for Clinical Research: An Approach Towards a Modern Herbal Medicinal Products Development. Front. Plant Sci. 2020, 11, 958. [Google Scholar] [CrossRef] [PubMed]
- Finn, D.P.; Haroutounian, S.; Hohmann, A.G.; Krane, E.; Soliman, N.; Rice, A.S.C. Cannabinoids, the Endocannabinoid System, and Pain: A Review of Preclinical Studies. Pain 2021, 162, S5–S25. [Google Scholar] [CrossRef] [PubMed]
- Gunasekera, B.; Davies, C.; Martin-Santos, R.; Bhatthacharyya, S. The Yin and Yang of Cannabis: A Systematic Review of Human Neuroimaging Evidence of the Differential Effects of Δ9-Tetrahydrocannabinol and Cannabidiol. Biol. Psychiatry Cogn. Neurosci. Neuroimaging 2020, 6, 636–645. [Google Scholar] [CrossRef] [PubMed]
- Sangiovanni, E.; Fumagalli, M.; Pacchetti, B.; Piazza, S.; Magnavacca, A.; Khalilpour, S.; Melzi, G.; Martinelli, G.; Dell’Agli, M. Cannabis sativa L. extract and cannabidiol inhibit in vitro mediators of skin inflammation and wound injury. Phytother. Res. 2019, 33, 2083–2093. [Google Scholar] [CrossRef] [PubMed]
- Antezana, P.E.; Municoy, S.; Pérez, C.J.; Desimone, M.F. Collagen Hydrogels Loaded with Silver Nanoparticles and Cannabis Sativa Oil. Antibiotics 2021, 10, 1420. [Google Scholar] [CrossRef]
- Miller, H.; De Leo, N.; Badach, J.; Lin, A.; Williamson, J.; Bonawitz, S.; Ostrovsky, O. Role of marijuana components on the regenerative ability of stem cells. Cell Biochem. Funct. 2021, 39, 432–441. [Google Scholar] [CrossRef]
- Weigelt, M.A.; Sivamani, R.; Lev-Tov, H. The therapeutic potential of cannabinoids for integumentary wound management. Exp. Dermatol. 2021, 30, 201–211. [Google Scholar] [CrossRef]
- Karas, J.A.; Wong, L.J.M.; Paulin, O.K.A.; Mazeh, A.C.; Hussein, M.H.; Li, J.; Velkov, T. The Antimicrobial Activity of Cannabinoids. Antibiotics 2020, 9, 406. [Google Scholar] [CrossRef]
- Blaskovich, M.A.T.; Kavanagh, A.M.; Elliott, A.G.; Zhang, B.; Ramu, S.; Amado, M.; Lowe, G.J.; Hinton, A.O.; Pham, D.M.T.; Zuegg, J.; et al. The antimicrobial potential of cannabidiol. Commun. Biol. 2021, 4, 7. [Google Scholar] [CrossRef]
- Luo, Y.; Li, Y.; Qin, X.; Wa, Q. 3D printing of concentrated alginate/gelatin scaffolds with homogeneous nano apatite coating for bone tissue engineering. Mater. Des. 2018, 146, 12–19. [Google Scholar] [CrossRef]
- Antezana, P.E.; Municoy, S.; Bellino, M.G.; Martini, M.F.; Desimone, M.F. Nanodelivery of the Gramicidin Peptide for Enhancing Antimicrobial Activity. Eur. J. Lipid Sci. Technol. 2021, 123, 2000389. [Google Scholar] [CrossRef]
- Municoy, S.; Antezana, P.E.; Pérez, C.J.; Bellino, M.G.; Desimone, M.F. Tuning the antimicrobial activity of collagen biomaterials through a liposomal approach. J. Appl. Polym. Sci. 2021, 138, 50330. [Google Scholar] [CrossRef]
- Paramasivam, S.; Shen, C.H.; Zourmand, A.; Ibrahim, A.K.; Alhassan, A.M.; Eltirifl, A.F. Design and Modeling of IoT IR Thermal Temperature Screening and UV Disinfection Sterilization System for Commercial Application using Blockchain Technology. In Proceedings of the 2020 IEEE 10th International Conference on System Engineering and Technology (ICSET), Shah Alam, Malaysia, 9 November 2020; pp. 250–255. [Google Scholar] [CrossRef]
- Singh, M.; Srivastava, M.; Kumar, A.; Pandey, K. Biosynthesis of Nanoparticles and Applications in Agriculture. In Role of Plant Growth Promoting Microorganisms in Sustainable Agriculture and Nanotechnology; Elsevier: Amsterdam, The Netherlands, 2019; pp. 199–217. [Google Scholar]
- Negrini, N.C.; Celikkin, N.; Tarsini, P.; Farè, S.; Święszkowski, W. Three-dimensional printing of chemically crosslinked gelatin hydrogels for adipose tissue engineering. Biofabrication 2020, 12, 025001. [Google Scholar] [CrossRef] [PubMed]
- McCullagh, A.; Sweet, C.; Ashley, M. Making a Good Impression (A ‘How to’ Paper on Dental Alginate). Dent. Updat. 2005, 32, 169–175. [Google Scholar] [CrossRef] [PubMed]
- Nandini, V.; Venkatesh, K.V.; Nair, K.C. Alginate impressions: A practical perspective. J. Conserv. Dent. 2008, 11, 37–41. [Google Scholar] [CrossRef]
- Distler, T.; McDonald, K.; Heid, S.; Karakaya, E.; Detsch, R.; Boccaccini, A.R. Ionically and Enzymatically Dual Cross-Linked Oxidized Alginate Gelatin Hydrogels with Tunable Stiffness and Degradation Behavior for Tissue Engineering. ACS Biomater. Sci. Eng. 2020, 6, 3899–3914. [Google Scholar] [CrossRef]
- Lafuente-Merchan, M.; Ruiz-Alonso, S.; Espona-Noguera, A.; Galvez-Martin, P.; López-Ruiz, E.; Marchal, J.; López-Donaire, M.; Zabala, A.; Ciriza, J.; Saenz-Del-Burgo, L.; et al. Development, characterization and sterilisation of Nanocellulose-alginate-(hyaluronic acid)- bioinks and 3D bioprinted scaffolds for tissue engineering. Mater. Sci. Eng. C 2021, 126, 112160. [Google Scholar] [CrossRef]
- Koch, M.; Włodarczyk-Biegun, M.K. Faithful scanning electron microscopic (SEM) visualization of 3D printed alginate-based scaffolds. Bioprinting 2020, 20, e00098. [Google Scholar] [CrossRef]
- Zabala, A.; A Blunt, L.; Tejero, R.; Llavori, I.; Aginagalde, A.; Tato, W. Quantification of dental implant surface wear and topographical modification generated during insertion. Surf. Topogr. Metrol. Prop. 2019, 8, 015002. [Google Scholar] [CrossRef]
- Cheung, H.-Y.; Lau, K.-T.; Lu, T.-P.; Hui, D. A critical review on polymer-based bio-engineered materials for scaffold development. Compos. Part B Eng. 2006, 38, 291–300. [Google Scholar] [CrossRef]
- Salem, A.K.; Stevens, R.; Pearson, R.G.; Davies, M.C.; Tendler, S.J.B.; Roberts, C.J.; Williams, P.; Shakesheff, K.M. Interactions of 3T3 fibroblasts and endothelial cells with defined pore features. J. Biomed. Mater. Res. 2002, 61, 212–217. [Google Scholar] [CrossRef] [PubMed]
- Sahoo, D.R.; Biswal, T. Alginate and its application to tissue engineering. SN Appl. Sci. 2021, 3, 30. [Google Scholar] [CrossRef]
- Wang, W.; Zhou, Z.; Liu, N.; Zhang, X.; Zhou, H.; Wang, Y.; Fang, K.; Wu, T. Improving Biocompatibility of Polyester Fabrics through Polyurethane/Gelatin Complex Coating for Potential Vascular Application. Polymers 2022, 14, 989. [Google Scholar] [CrossRef]
- Derkach, S.R.; Voron’Ko, N.G.; Sokolan, N.I.; Kolotova, D.S.; Kuchina, Y.A. Interactions between gelatin and sodium alginate: UV and FTIR studies. J. Dispers. Sci. Technol. 2020, 41, 690–698. [Google Scholar] [CrossRef]
- Derkach, S.R.; Voron’Ko, N.G.; Kuchina, Y.A. Intermolecular Interactions in the Formation of Polysaccharide-Gelatin Complexes: A Spectroscopic Study. Polymers 2022, 14, 2777. [Google Scholar] [CrossRef]
- Liu, Q.; Li, Q.; Xu, S.; Zheng, Q.; Cao, X. Preparation and Properties of 3D Printed Alginate–Chitosan Polyion Complex Hydrogels for Tissue Engineering. Polymers 2018, 10, 664. [Google Scholar] [CrossRef] [PubMed]
- Pedrosa, T.C.; Trócolli, R.; de Sousa, W.J.B.; de Cerqueira, G.R.C.; da Silva, H.N.; Barbosa, R.C.; de Souza, M.F.; Galdino, T.P.; Tissiani, J.N.A.; Fook, M.V.L. Development of Gelatin/Misoprostol Compounds for Use in Pregnancy Failures. Materials 2021, 14, 7250. [Google Scholar] [CrossRef] [PubMed]
- Xiao, Q.; Gu, X.; Tan, S. Drying process of sodium alginate films studied by two-dimensional correlation ATR-FTIR spectroscopy. Food Chem. 2014, 164, 179–184. [Google Scholar] [CrossRef] [PubMed]
- Xu, Z.; Han, S.; Gu, Z.; Wu, J. Advances and Impact of Antioxidant Hydrogel in Chronic Wound Healing. Adv. Health Mater. 2020, 9, 1901502. [Google Scholar] [CrossRef]
- Hacke, A.C.M.; Lima, D.; de Costa, F.; Deshmukh, K.; Li, N.; Chow, A.M.; Marques, J.A.; Pereira, R.P.; Kerman, K. Probing the antioxidant activity of Δ9-tetrahydrocannabinol and cannabidiol in Cannabis sativa extracts. Analyst 2019, 144, 4952–4961. [Google Scholar] [CrossRef]
- Foglia, M.L.; Mitarotonda, R.; De Marzi, M.C.; Desimone, M.F. Silicified collagen materials: Modulation of the in vitro and in vivo response. Mater. Sci. Eng. C 2019, 99, 47–56. [Google Scholar] [CrossRef] [PubMed]
- Desimone, M.F.; Hélary, C.; Mosser, G.; Giraud-Guille, M.-M.; Livage, J.; Coradin, T. Fibroblast encapsulation in hybrid silica–collagen hydrogels. J. Mater. Chem. 2010, 20, 666–668. [Google Scholar] [CrossRef]
- ISO 10993-5; Biological Evaluation OfMedical Devices Part 5: Tests for in Vitro Cytotoxicity. International Organization for Standardization International Organization for Standardization: Geneva, Switzerland, 2009.

| Freezing-Drying Step | Temperature (°C) | Time (h) | Pressure (mBar) |
|---|---|---|---|
| Freeze | −50 | 3 | - |
| Vacuum chamber | 0.2 | ||
| Primary drying | −50 20 | 5 7 | 0.2 0.2 |
| Secondary drying | 20 | 24 | - |
| Condition 1 | Condition 2 | Condition 3 |
|---|---|---|
| Mix gelatin + alginate, then add PBS and finally stir at 60 °C for 2 h. | Mix gelatin + alginate, then add PBS and finally stir at room temperature for 2 h | First add gelatin to PBS, then add alginate in PBS, mix these solutions and finally stir at 60 °C for 2 h. |
Publisher’s Note: MDPI stays neutral with regard to jurisdictional claims in published maps and institutional affiliations. |
© 2022 by the authors. Licensee MDPI, Basel, Switzerland. This article is an open access article distributed under the terms and conditions of the Creative Commons Attribution (CC BY) license (https://creativecommons.org/licenses/by/4.0/).
Share and Cite
Antezana, P.E.; Municoy, S.; Orive, G.; Desimone, M.F. Design of a New 3D Gelatin—Alginate Scaffold Loaded with Cannabis sativa Oil. Polymers 2022, 14, 4506. https://doi.org/10.3390/polym14214506
Antezana PE, Municoy S, Orive G, Desimone MF. Design of a New 3D Gelatin—Alginate Scaffold Loaded with Cannabis sativa Oil. Polymers. 2022; 14(21):4506. https://doi.org/10.3390/polym14214506
Chicago/Turabian StyleAntezana, Pablo Edmundo, Sofía Municoy, Gorka Orive, and Martín Federico Desimone. 2022. "Design of a New 3D Gelatin—Alginate Scaffold Loaded with Cannabis sativa Oil" Polymers 14, no. 21: 4506. https://doi.org/10.3390/polym14214506
APA StyleAntezana, P. E., Municoy, S., Orive, G., & Desimone, M. F. (2022). Design of a New 3D Gelatin—Alginate Scaffold Loaded with Cannabis sativa Oil. Polymers, 14(21), 4506. https://doi.org/10.3390/polym14214506

